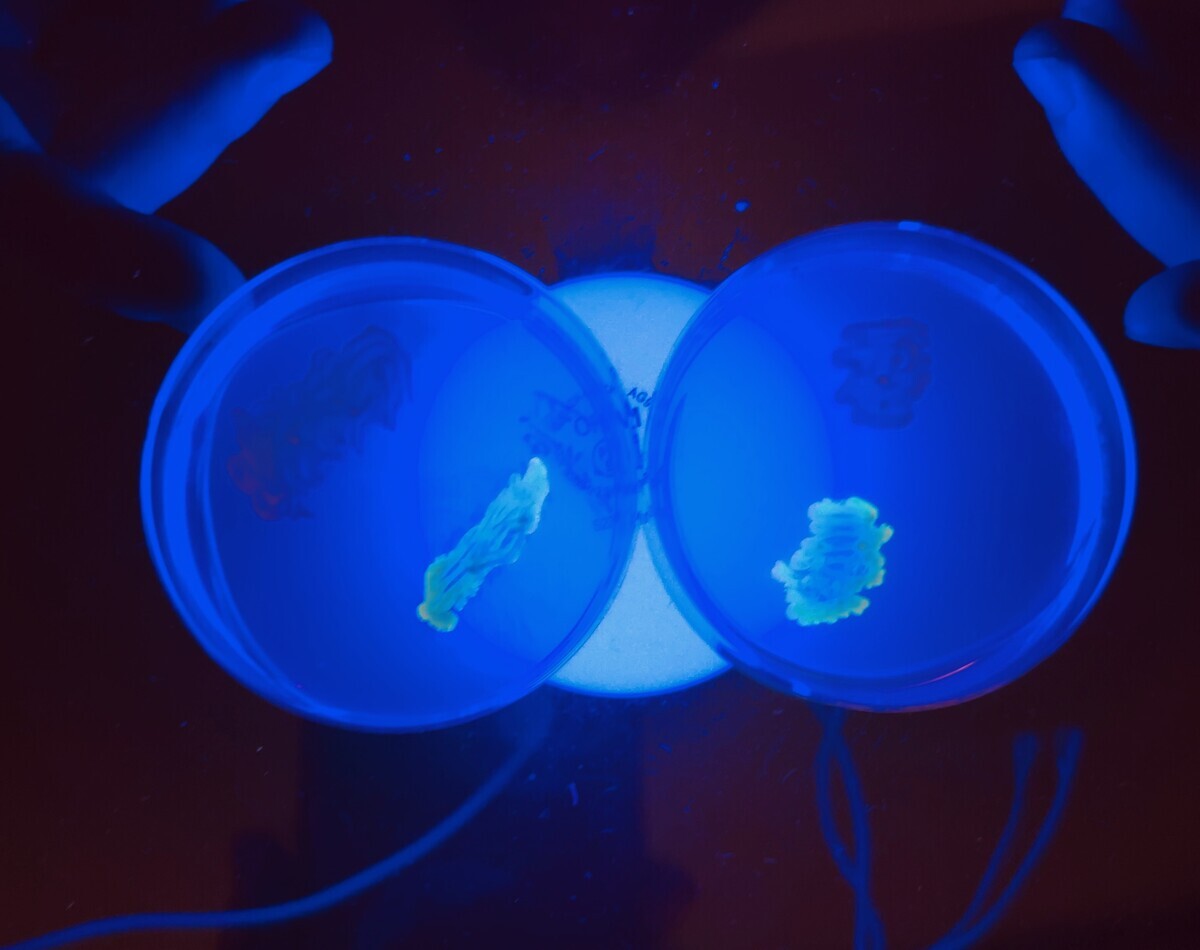

今日の一句 サングラスかけて世の中見渡せり 浮浪雀
今日の三択。北海道「木彫りの熊」戦前のブームのきっかけは? 海外旅行・美術の授業・ぼけ スイス旅行の土産物だったという。
今日は夏休み前授業最後の日。2コマ、2コマ、片付けて出欠入力して、休暇届出して撤収。昼メシは恒例の vie de france のパンと牛乳670円。3時44分撤収。
昨日から社会保険料の通知が来ている。記録しておく。国民健康保険は40,800円納入先は三鷹市の保険課。通帳から引かれる。次が介護保険。128,400円これは公的年金から特別徴収。そして最後の大物が後期高齢者医療保険料、396,300円。これは市の市民部が納入先。収入に応じて、所得額の9.67%を取られる。消費税どころの騒ぎではない。所得の1割がこれに持っていかれる。それプラス均等割の47,300円、それで40万近い金が飛ぶ。これは私が週2回満員電車に揺られて通勤して稼いだ日銭の5ヶ月分である。仕事すれば収入が増えずに保険料が増える。幸い私は大きな病気をしていないが、医療費がかかっている人のために援助していることになるのだ。全部で合計して565,500円。所得税・消費税とは別にこれだけ年額取られる。これが少子高齢化ってやつですか。76歳で週4日働いてこの仕打ちですか。モチベ下がるね。
物理・情報を少しやる。さんずうゼミのネタを作らないと。